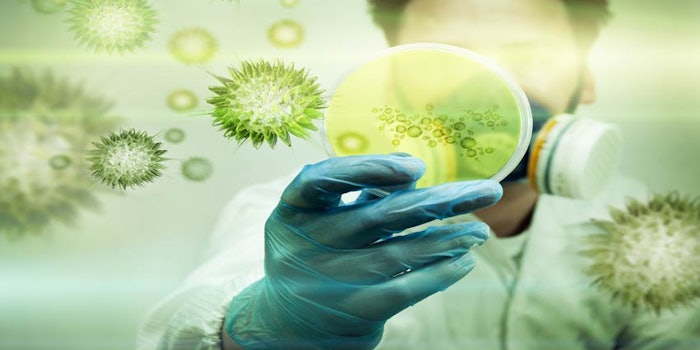

Omega Ingredients, after a three-day audit by Isoquar to the BRC Global Food Standard, was awarded a AA grade to version 7 with additional approval for the Traded Items Module. The audit assesses food safety standards across the supply chain and sets the standards for manufacturing prices.
Recognizing Safety and Innovation
The award recognizes the company's commitment to procedure, training, competency, food safety and risk management.
The award also acknowledged success for the company’s newest product, ΩMegaSweet.a The natural flavor system is used to combat sugar reduction in the beverage industry and enables sugar reduction up to 50%.
“Our success in the BRC audit underpins the continuous improvement which is at the heart of our business. The whole team has worked together to ensure that the requirements of the audit have been met and exceeded – they’ve become our standard practice. This culture of excellence has been built into the business by us all and this AA Award acknowledges the contribution of each and every single member of the team," said Steve Pearce, CEO of Omega Ingredients.
a ΩMegaSweet is a registered tradename of Omega Ingredients.